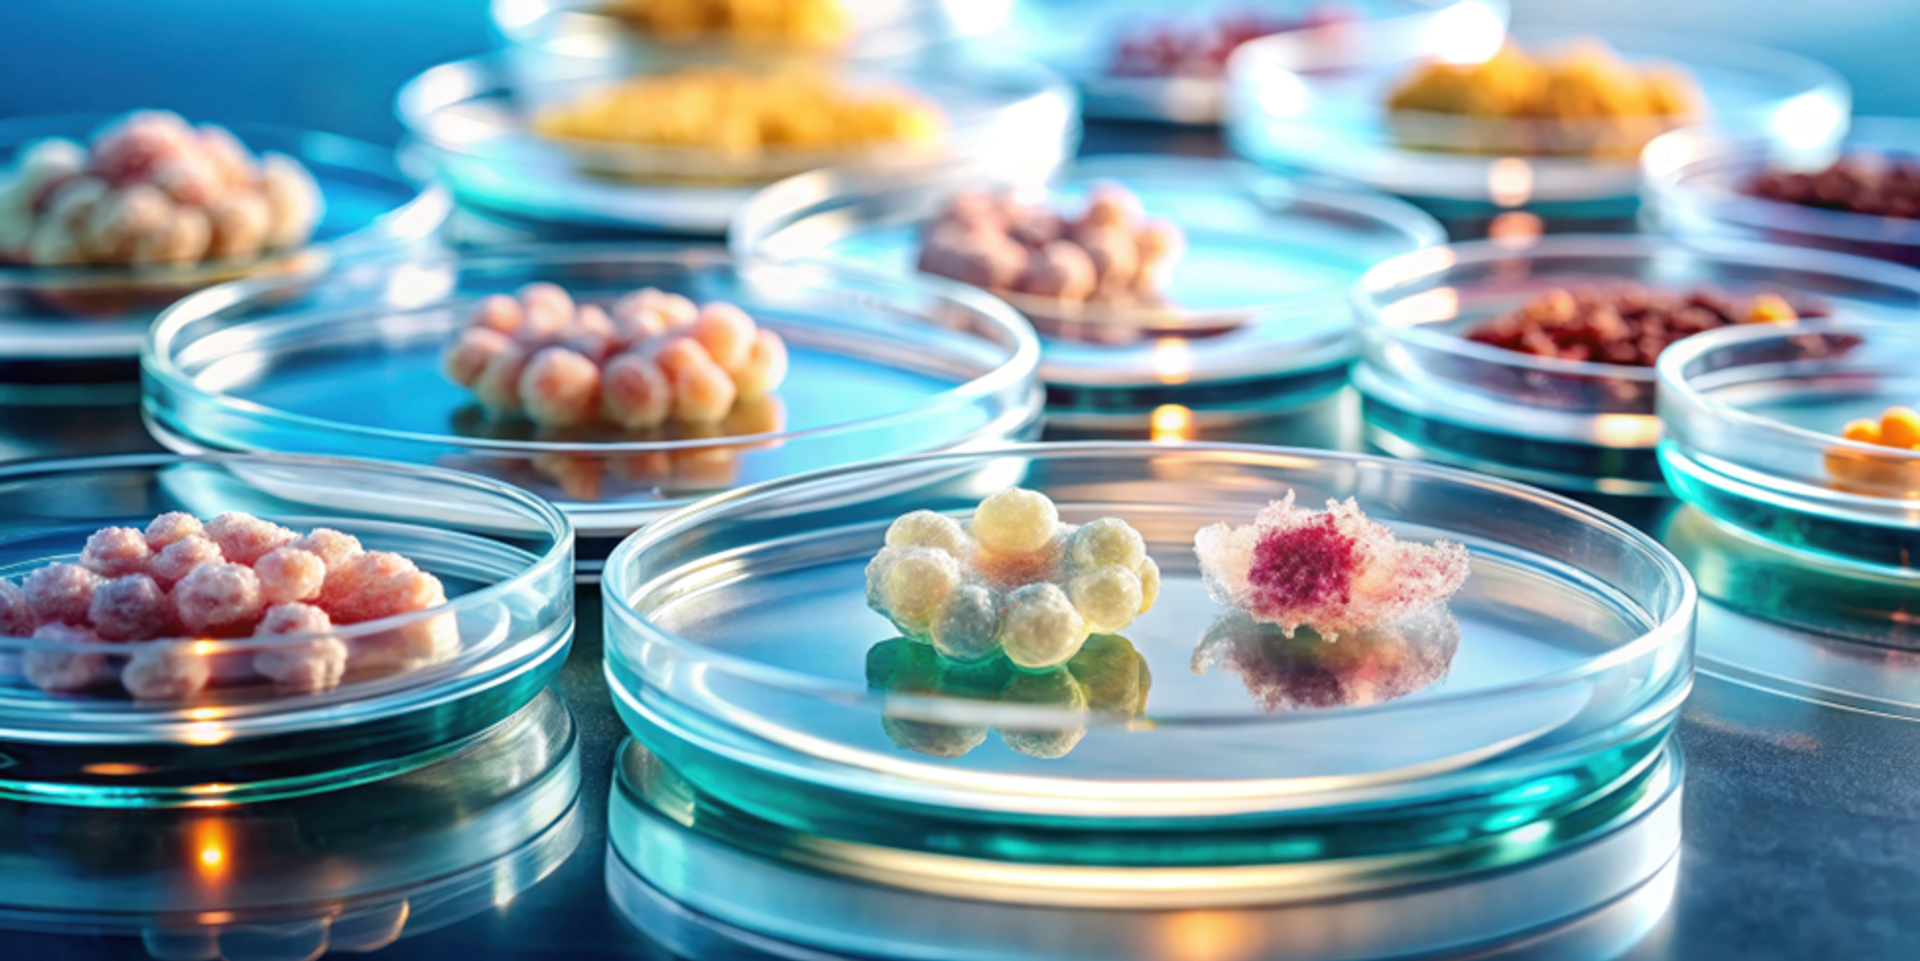

The power of 3D cell cultures explored in podcast
Guest editorial features key takeaways from Balancing the Future Podcast, episode 2, by METTLER TOLEDO
30 May 2025
Dr. Jan Lichtenberg, CEO and co-founder of InSphero
In the rapidly evolving landscape of drug development and testing processes, traditional paradigms are being challenged and transformed by innovative approaches that promise to enhance efficacy and safety. A recent episode of METTLER TOLEDO’s podcast 'Balancing the Future' highlights one of the most transformative advances in this space: 3D cell cultures. At the heart of this exciting exploration is Dr. Jan Lichtenberg, CEO and co-founder of InSphero, a global leader in scalable 3D in vitro solutions for drug safety and efficacy testing.
Listen to Balancing the Future Podcast, Episode 2, by METTLER TOLEDO on your favorite streaming platform: Spotify, Apple Podcasts, YouTube , or Amazon Music.
Read on to hear highlights from the conversation
In this episode, Dr. Jan Lichtenberg articulates the critical limitations inherent in conventional 2D cell cultures that have dominated preclinical testing. "Biology is not flat," he asserts, underscoring the inadequacies of 2D systems in mimicking the complex microenvironments found in vivo. These flat cultures fail to accurately replicate the intricate cellular interactions in three dimensions, resulting in significant gaps in our understanding of drug responses and toxicological profiles.
One stark example is the use of liver cells (hepatocytes) in 2D culture, where their functionality deteriorates rapidly, leading to misleading results in drug metabolism studies. Moreover, traditional methodologies often overlook delayed toxicity, which can emerge only after extended exposure to a pharmaceutical agent, raising critical safety concerns for drugs that clear initial trials.
Transitioning to 3D cell culture systems represents a paradigm shift in how researchers model human biology. These advanced cultures provide a more physiologically relevant context closely mirroring the complexities of human tissues. Dr. Lichtenberg explains the transformative potential of these models, emphasizing their ability to integrate multiple cell types to recreate tissue architecture and function. This is akin to an orchestra, where the harmonious interplay of diverse instruments produces a rich and nuanced performance, far superior to that of any solo player.
In the 3D format, we can put all these different cell types into a meaningful context, which allows these models to be more predictive than a classical 2D cell culture. And that's a huge win for research.
Dr. Jan Lichtenberg CEO and co-founder of InSphero
The episode adeptly navigates the scientific intricacies of 3D cultures, revealing their capability to enhance the predictive accuracy of drug testing. By cultivating organoids—miniaturized, simplified versions of organs—researchers can closely simulate human biological systems, providing a more reliable platform for evaluating drug efficacy and safety.
Organoids cultured in a petri dish on a nutrient-rich growing medium, with cells organized in layered formations to create a three-dimensional structure.
As the episode unfolds, it becomes evident that the advent of 3D cell cultures has paved the way for personalized medicine. By utilizing patient-derived cells to generate specific disease models, researchers gain invaluable insights into individual variability in drug responses. This approach not only holds promise for tailoring therapies to meet the unique needs of patients but also addresses significant gaps in the treatment of rare diseases that often struggle to attract research investment.
Dr. Lichtenberg emphasizes that by creating precise disease phenotypes, 3D cell cultures can reinvigorate interest in neglected conditions, thereby catalyzing pharmaceutical investments where they are most needed. This renewed focus could lead to breakthroughs that significantly enhance the quality of life for patients with rare and complex diseases.
Despite the remarkable advantages of 3D cell culture technology, several challenges remain. Chief among them is the regulatory landscape, which still heavily favors traditional testing methods. However, recent legislative movements, such as the FDA Modernization Act 2.0, indicate a shifting tide toward recognizing the value of alternative methods, including 3D cultures.
The road ahead will require compelling evidence to demonstrate the predictive validity of these innovative technologies to regulatory bodies and the broader pharmaceutical community. As the scientific dialogue continues and more data emerge, there is hope that regulatory frameworks will evolve to embrace these advanced methodologies.
Discover how this episode of "Balancing the Future" showcases the integration of 3D cell culture technologies into drug development as a groundbreaking advancement that provides a more nuanced and accurate alternative to traditional testing methods. With the potential to revolutionize personalized medicine and foster innovation in drug discovery, 3D cell cultures stand poised to transform the future of healthcare. As researchers, regulators, and industry stakeholders unite in this endeavor, the promise of safer, more effective pharmaceuticals is becoming an increasingly tangible reality.